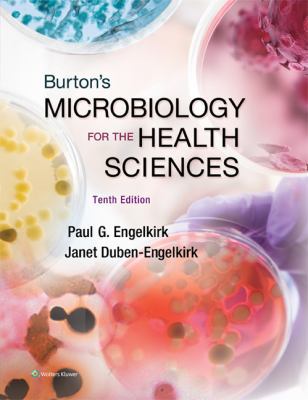

All Formats & Editions
1 - 1 of 1 results found
BURTON'S MICROBIOLOGY FOR THE HEALTH SCIENCES 1...
By Paul Engelkirk and Paul G. Engelkirk
Edition Description
Prepare your students for success in their future careers with Burton's Microbiology for the Health Sciences, 10e. Featuring a clear and friendly writing style that emphasizes the relevance of microbiology to a career in the health professions, the Tenth Edition offers a dramatically...
Edition Details
Format:Paperback
Language:English
ISBN:1451186320
Format: Paperback
Condition:
$
13.59
Save $95.36!
List Price: $108.95
Almost Gone, Only 1 Left!



